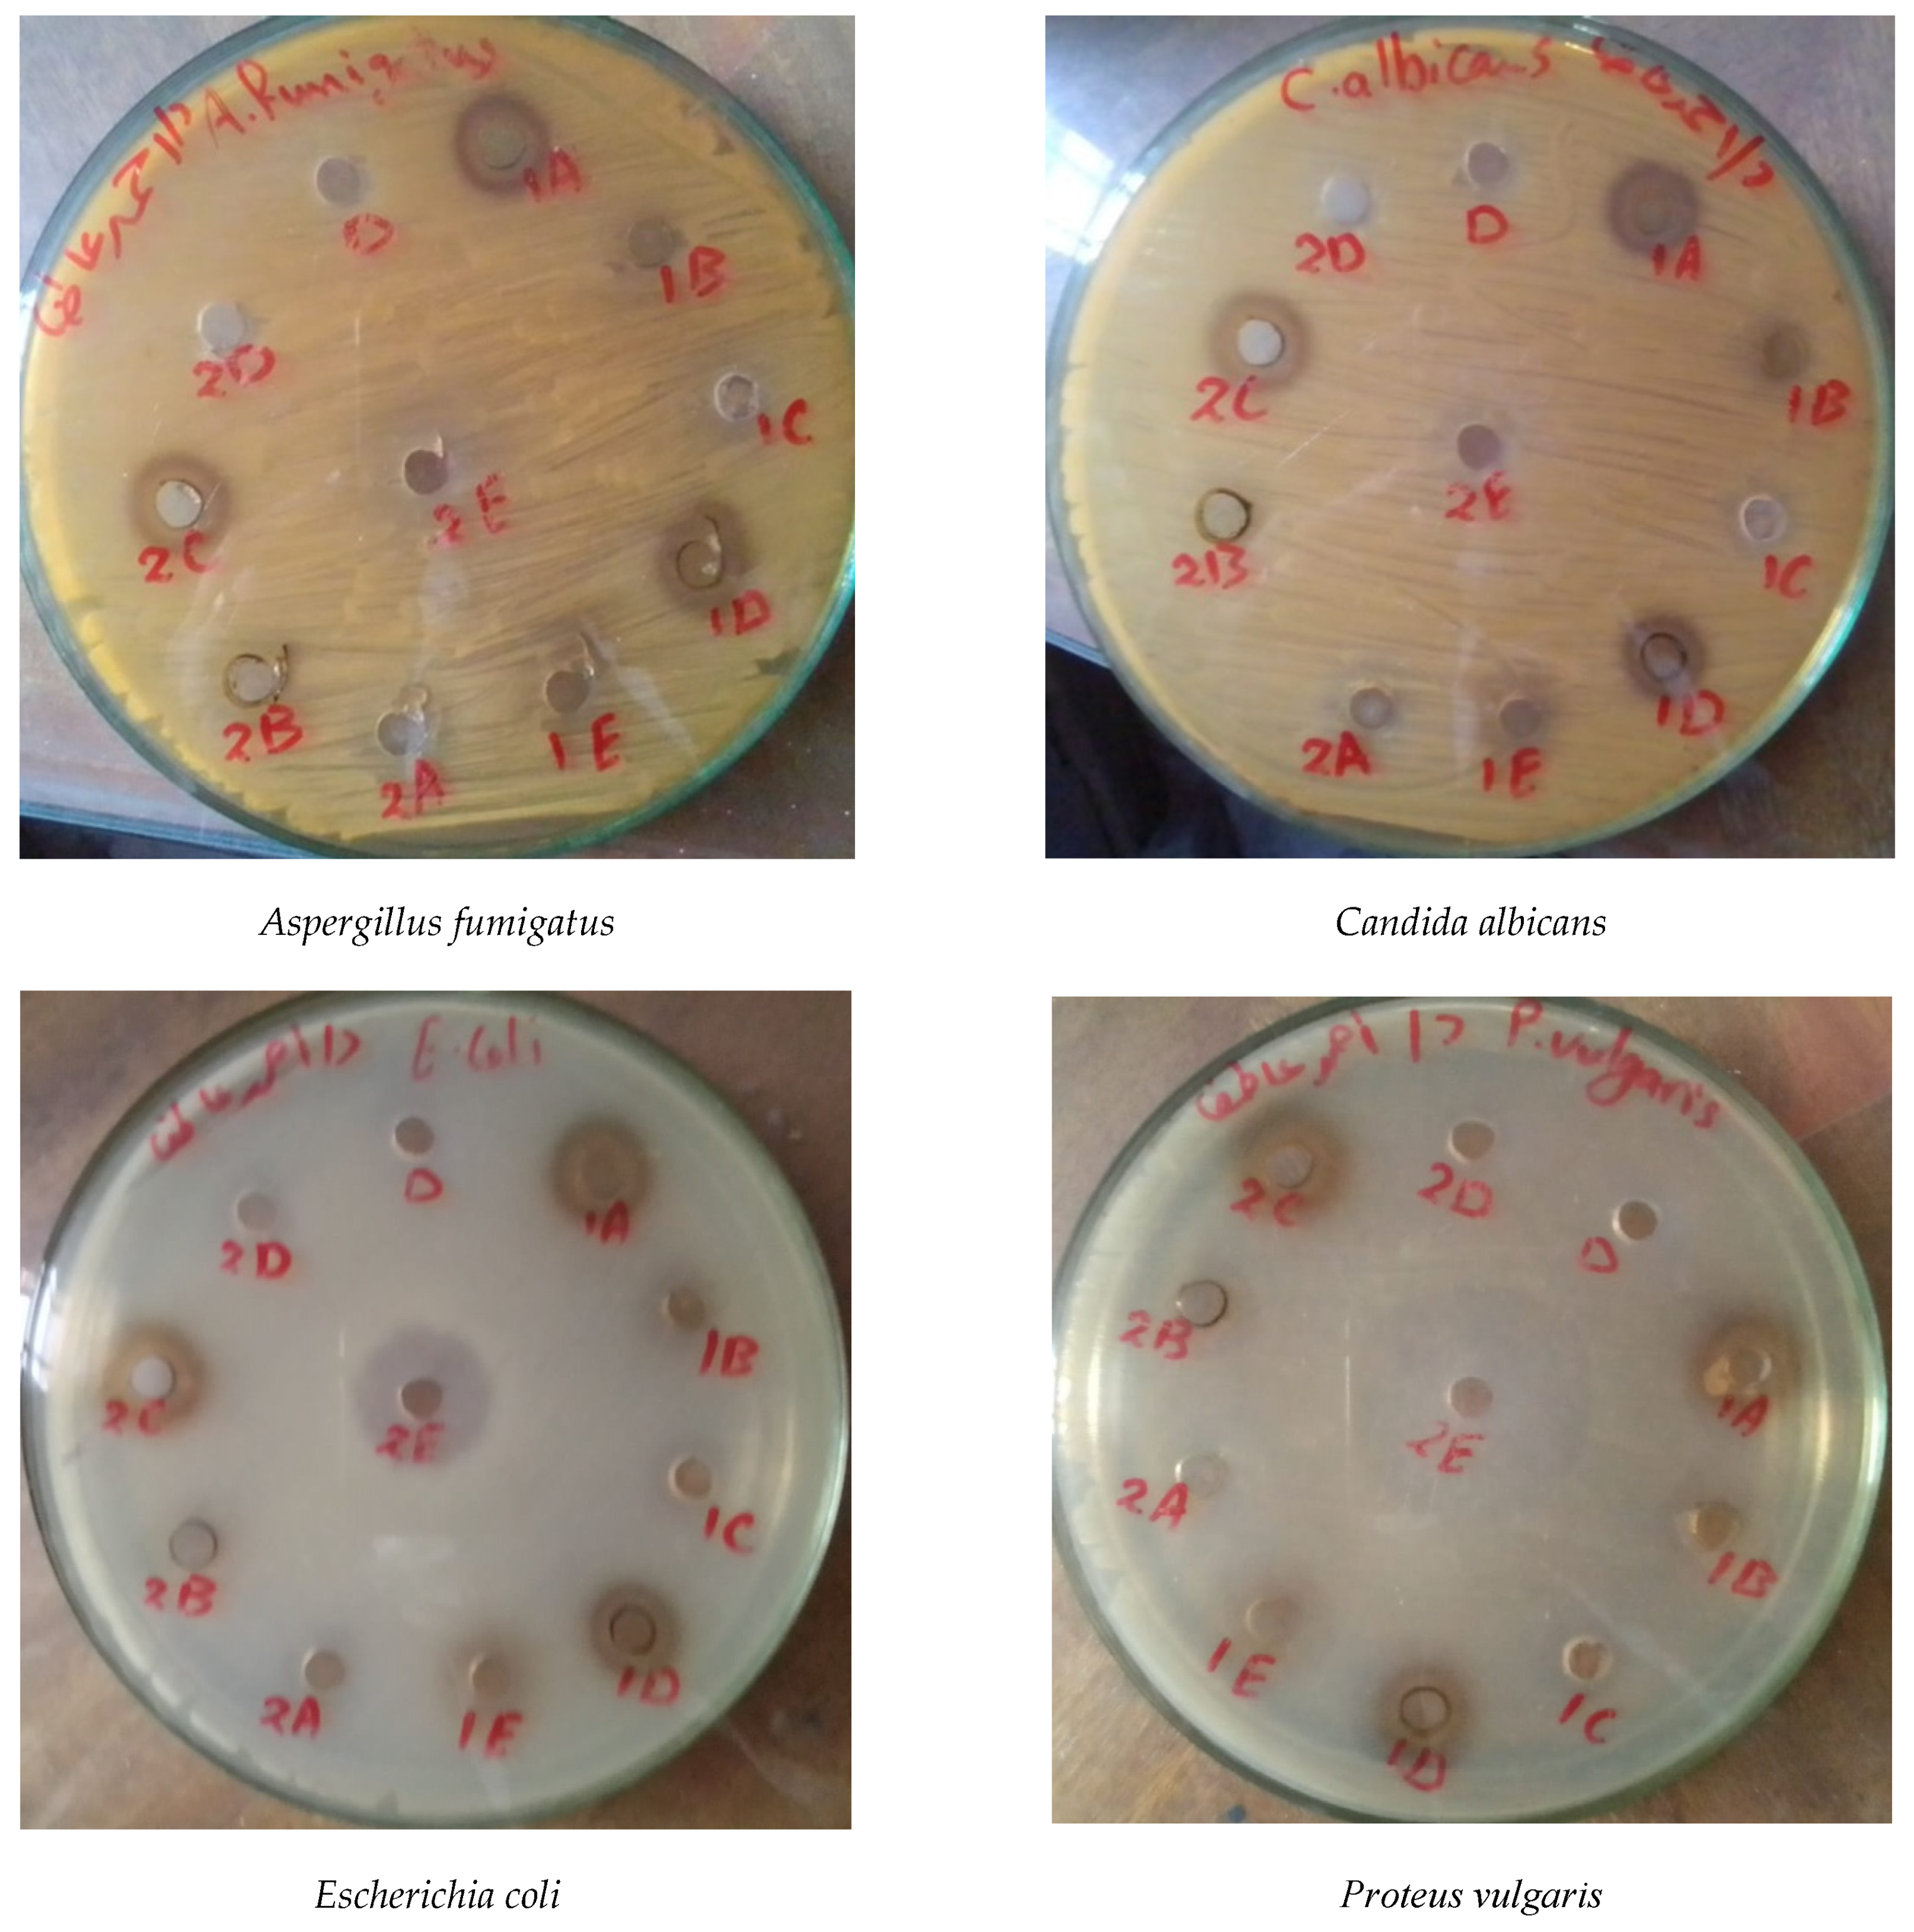
Life 12 00273 g004a 550

1. Introduction
Rosa damascena Mill. var.
trigintipetala (Taif’s rose or Damask rose), a Rosaceae plant, is one of the most important commercial crops farmed due to the high value of its essential oils worldwide [
1]. It is a tall shrub that can reach 2.5 meters in height and blooms once a year (in May–June), with a fully mature plant producing 500–600 flowers [
2]. Taif’s rose grows in temperate and subtropical climates at elevations ranging from 300 to 2500 meters [
3]. It is commercially grown in Saudi Arabia, Egypt, Turkey, Morocco, Bulgaria, Iran, France, China, and India, among other countries [
4]. It is also one of the attractive and aromatic plants grown for use in the perfume, pharmaceutical, and food industries in numerous Taif governorate locations [
5]. In contrast to the Bulgarian variety, the Saudi Arabia rose oils do not fully comply with the ISO 9842:2003 standard for rose oil, but they have a high olfactive potential [
6]. Taif’s rose has been shown to have antioxidant, antidiabetic, anti-HIV, antibacterial, anti-inflammatory, and cardiotonic properties due to the presence of various phytochemical compounds such as alkaloids, phenolic acids, flavonoids, and other phenolic compounds [
7,
8,
9].
In terms of the current state of the Taif rose, the governorate of Taif has approximately 860 farms ranging in size from large (1.0 ha) to small (0.03 ha) with most of them ranging from 0.3 to 0.7 ha. This variation in size may be due to the cultivation conditions of the Taif rose on mountain ridges and in wadi beds, which differs from the corresponding species worldwide. The wastes generated by these farms (>2700 ton) could be agriculturally produced from rose bush pruning and industrially created from the oil distillation process [
10]. A tiny portion is used for vegetative propagation, but the majority is dried and burned, posing environmental issues such as air and soil pollution, as well as health risks to surrounding residents [
11]. The output of Taif rose blooms, and thus the highest oil percentage, is closely related to trimming [
12]. Pruning is carried out such that the lower branches get sufficient light to create food, changing growth phases to encourage new axillary and bloom buds, and removing disease dependent on the variety [
1].
Thousands of plant species are employed in many traditional systems of medicine around the world and are recognized for their contributions to contemporary medicine, with some of them, such as
Brugmansia and
Rosa species, being used to treat cancer and cardiovascular problems [
13,
14]. The use of medicinal plants is a centuries-old tradition, and recent advances in contemporary therapies have boosted the use of natural products for a variety of maladies and disorders around the world [
15]. Secondary metabolites have a variety of biological effects, and they provide the scientific foundation for many ancient civilizations’ uses of herbs in traditional medicine [
16]. Phenolic compounds are widely distributed and the most abundant secondary metabolites in plants; they include flavonoids, alkaloids, and phenolic acids, which are involved in the defense against ultraviolet radiation or aggression by pathogens, parasites, and predators [
17]. These secondary plant metabolites were investigated for their activity against cardiovascular and neurodegenerative diseases and cancer [
17,
18].
Pharmacological investigations have demonstrated that rose blooms of Taif provide a wide range of health benefits due to their high polyphenolic content [
19]. According to Karkania et al. [
20],
R. damascena has potential antimicrobial activities against both Gram-negative and Gram-positive bacteria as well as fungi. Moreover, strong antimicrobial activity has been reported against different bacterial and fungal strains such as
Escherichia coli,
Proteus vulgaris,
Candida albicans, and
Staphylococcus aureus [
21,
22]. On a scientific level, empirical knowledge from folk medicine is becoming an increasingly important component of in vitro and in vivo studies, including preclinical and clinical trials. These studies investigated and explained the therapeutic efficacy of rose products and their ingredients, such as antidepressant effects, psychological relaxation, sexual dysfunction improvement, antioxidant, antimicrobial, antifungal, probiotic, and antipyretic effects, smooth muscle relaxation, lipid-lowering content, antiulcerogenic effects, and so on [
4,
23,
24,
25].
Because of the associated transportation, storage, and processing requirements, direct burning of agricultural biomass or trash is not cost-effective [
20]. Furthermore, inappropriate agricultural waste storage pollutes the environment (soil, air, water, and sight) [
26]. Several studies were carried out on the pharmacological activity of the essential oil of Taif’s rose [
6,
27], while, to the authors’ knowledge, no studies have been conducted on the recycling of its vegetative wastes. As a result, recycling and reusing these solid wastes for commercial purposes is extremely important and essential. As a result, the current study intends to investigate the phytochemical elements including cardiac glycosides, flavonoid, alkaloids, and other phenolic compounds, of Taif’s rose pruning wastes and their pharmacological potential as a phytomedicine. These compounds, in addition to having antioxidant properties, have several other specific biological actions in preventing and/or treating diseases.
4. Discussion
The pruning of Taif’s rose is a horticultural art for manipulating plant architecture to force the plant into artificial rest or a dormant period before flowering [
11]. Pruning waste disposal by drying and burning or storage causes environmental pollution [
28]. In the current study, the biomass of the pruning wastes ranged between 1.3 t FW ha
−1 and 5.2 t FW ha
−1 in F4 (youngest farm) and F3 (oldest farm), respectively. According to Al-Yasi et al. [
5], approximately 860 farms with different areas in the Taif governorate and its suburbs are cultivated with Taif’s rose, which produces approximately 2730 tons of pruning waste and can cause a tremendous environmental problem. Therefore, it is of great importance and urgent need to recycle these agricultural wastes and reuse them for various economic purposes.
Carbohydrates are energy-rich molecules that play an important role in the immune system, pathogenesis, blood clotting, fertilization, and protein folding and placement. Their determination in plants is important for quality control analysis, as they are bioinformative macromolecules [
38]. It was found that Taif’s rose leaves had higher carbohydrate contents than the stems, where the contents ranged between 0.78% in the stem and 3.05% in the leaves. These values were comparable to 0.25–4.05% in the leaves of the medicinal aloe plants [
39], but lower than 9.0–16.3% recorded in the leaves of
Calotropis procera [
40]. The high carbohydrate content in the leaves may be a response to the drought stress of rose plants before and after pruning [
5]. In addition, the accumulation of carbohydrates may be due to the reduction in their utilization, either as a source of energy or for the formation of new cells and tissues or as an osmolyte of the cells [
41]. According to Chesney and Vasquez [
42], the biosynthesis of carbohydrates is influenced by pruning practices, and the stored carbohydrates can be used for plant regrowth [
12].
The use of herbal/natural drugs as complementary/alternative medicines is gaining popularity throughout the world and many drugs are directly extracted from plants, whereas others are chemically modified [
14]. Phytochemical exploration of the ethanolic extract of the Taif’s rose stem and leaves revealed the presence of cardiac glycosides, alkaloids, and phenolic compounds. Similar findings were reported by Fathima and Murthy [
43] in the petals of the same species. According to Alzletni et al. [
44], the determination of these phytochemical compounds is important to show the nutritional and medicinal value of plants. Notably, the Taif rose stem had higher cardiac glycoside and flavonoid contents, while the plant leaves had higher phenolic and alkaloid contents. According to Baydar and Baydar [
7], Taif’s rose leaf extracts were rich in phenolic acids, including ferulic and gallic acids, and flavonoids, including catechin, compared to the other extracts. Cardiac glycosides are a type of secondary metabolite that has traditionally been utilized to augment cardiac contractile force in individuals suffering from cardiac arrhythmias or congestive heart failure [
45]. Their contents ranged between 2.98 mg g
−1 in the leaves of the oldest farm and 5.69 mg g
−1 in the stems of the youngest farm. These values were lower than the 9.5–15.2 mg g
−1 and 9.07–21.09 mg g
−1 recorded in
C. procera [
40] and
Aloe spp. [
39], respectively.
Plant-based secondary metabolites are known to represent several structurally diverse classes of polyphenols with potential pharmacological activities, including anticancer, anti-inflammatory, antioxidant, and antipathogenic properties [
46]. The plant leaves from the oldest farm had the highest phenolic contents (12.41 mg g
−1), while the stems of the youngest farm had the lowest (3.14 mg g
−1). These values are lower than the 386.4 mg g
−1 recorded in the flower residue of Taif’s rose [
47] and 4.21–25.02 mg g
−1 recorded in
Aloe spp. [
40]. This means that the pharmacological activities (antioxidant, anti-ageing, whitening, antitumor) of the flowers are greater than those of leaves and stems. According to Nayebi et al. [
19], the cardioprotective effect of Taif’s rose bioactive phenolics may be attributed to the inhibition of the enzymes related to atherosclerosis and hypertension. In addition, several investigations have demonstrated the antibacterial and disinfectant activity of Taif’s rose and indicated the role of large phenolic contents such as flavonoids, terpenoids, and phenyl ethyl alcohol [
20]. The highest flavonoid content (9.33 mg g
−1) was recorded in the stems of Farm 2 plants, while the lowest (5.09 mg g
−1) was found in the leaves of Farm 3 plants.
Ellagic acid, catechol, resorcinol, gallic acid, and phloroglucinol were the main phenolic compounds separated and identified using HPLC in Taif’s rose extract. The content of gallic acid as the main indicator in Taif’s rose ranged between 5.6 and 37.4 mg g
−1, which is lower than the 50.3 mg g
−1 recorded in the flower residue of the same species [
48], 7.21–40.12 mg g
−1 recorded in
Aloe spp. [
39]. Investigations have shown that gallic acid possesses a lot of biological activities such as antioxidant properties, antimicrobial activity, anti-inflammatory, antiviral, and antimutagenic activities, and anticancer activity [
49,
50]. Gallic acid also has anti-biofilm activity versus
Staphylococcus aureus [
51]. Moreover, quercetin is an abundant polyphenolic flavonoid that provides many health-promoting benefits such as being potent vasodilatory agents, cancer-reducing agents, anti-inflammatory, protective against asthma, and many others [
52]. Furthermore, ellagic acid is an important compound used as an anticarcinogenic, multifunctional protector against oxidative stress and an anti-inflammatory agent in the treatment of chronic ulcerative colitis [
4,
53,
54].
HPLC analysis showed that Taif rose leaves and stems produced flavonoid compounds including luteolin, apigenin, quercetin, rutin, kaempferol, and chrysoeriol. These compounds have potential antioxidant, anti-inflammatory, and antimicrobial properties [
54]. Moreover, according to Dahat et al. [
55], quercetin and its glycoside rutin have been reported in extracts displaying nephroprotective properties. In addition, luteolin and apigenin have been shown to inhibit the viability of leukemic cells, colon and ovarian carcinoma cells, and particularly human breast cancer cells, as well as reduce the occurrence of mouth sores and induce mild symptomatic relief [
56]. Quercetin also helps protect against certain types of cancers, especially colon cancer [
49], reduces the occurrence of mouth sores, and helps to induce mild symptomatic relief [
52]. Moreover, alkaloids are biologically active compounds widely used as pharmaceuticals and synthesized as secondary metabolites in plants, and many of these compounds are highly toxic [
13,
15]. Berbamine, jatrorrhizine, palmatine, reticuline, isocorydine, and boldine were the main alkaloid compounds in Taif’s rose. These compounds are common constituents of many Chinese medicinal plants and are known to have antibacterial, anti-inflammatory, anticancer, and choleretic properties as well as promote leukocytosis [
57]. According to Duke [
58], the long-term consumption of boldine led to color hallucinations, depression, partial motor aphasia, and sound hallucinations. High excitement exaggerates reflexes and respiratory movements, increases diuresis, causes cramps and convulsions, ends in death from centric respiratory paralysis, and heartbeats sometimes fail after respiration.
The antimicrobial activity of a plant depends on the phytogeographical area, the plant part, and the extraction process [
59]. The pharmacological properties of Taif’s rose leaf extracts showed that the boiling water extract was moderately active against all studied bacterial and fungal strains, and the remaining extracts had no antifungal activities. Gram-positive (
B. subtilis), and gram-negative (
E. coli, and
P. vulgaris) bacteria were highly sensitive to warm water extracts compared with gentamicin antibiotics (control). In a similar study on
Rosa indica extracts, Saeed et al. [
60] found antibacterial activity against
Proteus sp. and
E. coli, and antifungal activity against
A. fumigatus strains. The most effective reason is the presence of various phytochemical compounds such as alkaloids, phenolic acids, flavonoids, tannins, and other phenolic compounds. According to Baydar and Baydar [
7], the total phenolics were higher in the cold and hot extractions of the leaf. In addition, the total phenolic and flavonoid contents have a good correlation with antioxidant activity [
61], which is an important factor in assessing the biological activity of medicinal plants in the rose species [
62]. Moreover, Samuelsen [
63] and Abd Razik et al. [
64] attributed the antimicrobial activity to the presence of some intermediately polar or nonpolar substances of relatively low molecular weight in the plant extract.
The methanol and cold water extracts of the stem were active against all studied bacterial and fungal strains; however, the remaining extracts had no activity against fungal strains. Similar findings reported that the methanol extract of
P. major showed higher antimicrobial activity than the ethanol extract [
55,
65]. According to Norziah et al. [
66], the use of water as the extracting solvent is more desirable than the use of organic solvents due to its environmentally friendly and non-toxic characteristics. Moreover, water is a good solvent in extracting a considerable quantity of phenolic and flavonoid compounds with high activities that can safely be exploited in numerous food applications. In one study, the intraperitoneal administration of 10 mg kg
−1 of
R. damascena Mill. methanolic extract in infected mice significantly reduced the parasitemia of
Plasmodium berghei [
19]. It was clear that
P. vulgaris was highly susceptible, while
B. subtilis was moderately sensitive against all stem extracts. Similar results were reported by Halawani [
67] on the different extracts of
R. damascena. Conversely, the aqueous extract of the medicinal plant
P. major has no antimicrobial activity [
55]. Therefore, pharmaceutical studies are required to separate, purify, and identify the phytochemical compounds in the ethanolic, methanolic, and water extracts of the pruning wastes of Taif’s rose. In addition, the antibacterial activity of each compound was investigated to determine the compound/s that has antibacterial activity against pathogenic microorganisms.